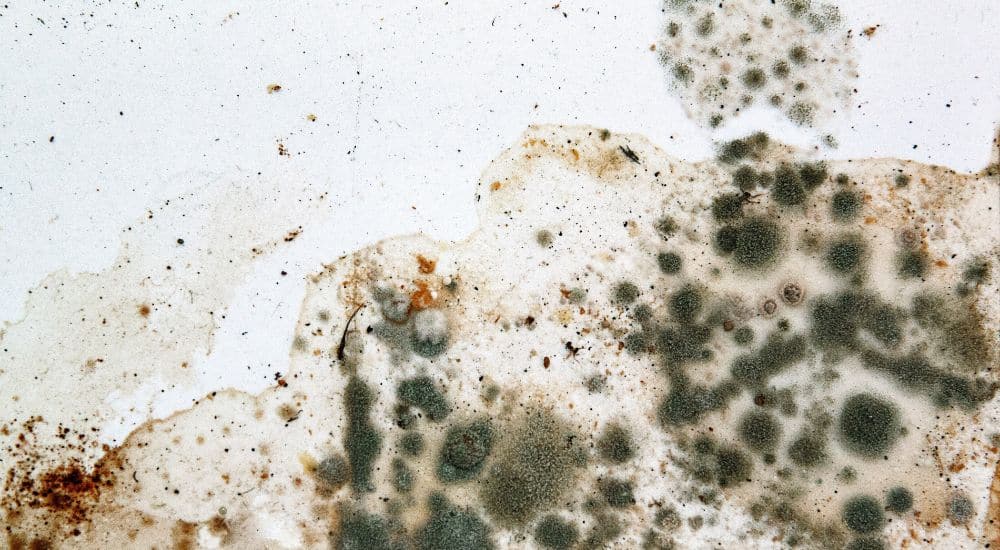
Huiszwam-1

Inhoud
Wat kost het bestrijden van huiszwam?
De kosten voor het laten bestrijden van een huiszwam in een vroeg stadium liggen gemiddeld rond € 2.500 tot € 3.500. Laat je de huiszwam bestrijden in een later stadium, dan mag je rekenen op een prijs van € 6.000 tot € 10.000.
Dat is natuurlijk slechts een richtprijs. Enkele factoren die de kosten beïnvloeden:
- Ernst van de zwamgroei
- Oppervlakte en ernst van de aantasting
- Nodige herstelling
Het is dus zeker aan te raden om een specialist in te schakelen zodra je de huiszwam aantreft. Zelfs bij een vermoeden van huis- of kelderzwam is het verstandig om een expert te raadplegen.
Verzekering: vergoeding huiszwammen
In sommige gevallen kun je rekenen op een tussenkomst van de verzekering. Als je kan aantonen dat de zwamgroei geen gevolg van nalatigheid is, kan je rekenen op een vergoeding.
Dat kan bijvoorbeeld het geval zijn wanneer een verborgen lek ongemerkt voor vochtproblemen heeft gezorgd. Als de huiszwam gedijt in het vocht van dat lek, dan kan de verzekeraar oordelen dat de zwamgroei niet te voorkomen was. Een ander voorbeeld is een vochtprobleem dat bij de buren ontstond.
Welke kosten dekt de verzekeraar? Het gaat doorgaans om gevolgschade. Bijvoorbeeld …
- Herstellen van muren, vloeren en plafonds
- Openbreken van muren
Hoe herken je huiszwam?
Hoe kun je een huiszwam herkennen? De huiszwam is een soort paddenstoel en dus eigenlijk een schimmel. Een huiszwam bestaat uit twee delen.
Hoe ziet een huiszwam eruit?
Het vruchtlichaam is het zichtbare deel van de huiszwam dat je makkelijk kan herkennen. Dat vruchtlichaam is rond en heeft een bruinrode kleur. Het vruchtlichaam is ongeveer 1 centimeter dik.
Daarnaast heeft de huiszwam, net als andere soorten schimmels, schimmeldraden. Die draden groeien uit de sporen waarmee de zwam zich verspreid. Het zijn in feite de wortels van de zwam. Ze voorzien het vruchtlichaam van vocht en voedingsstoffen.
Aanvankelijk zijn de schimmeldraden doorzichtig en kun je ze nagenoeg niet waarnemen. Na een tijdje krijgen de schimmeldraden witte randen. Naarmate ze zich verder ontwikkelen, worden ze donkerder van kleur. Net als het vruchtlichaam zijn de volgroeide schimmeldraden donker- of roodbruin.
De schimmeldraden opmerken gebeurt soms bij toeval. Meestal tref je de huiszwam pas aan wanneer het vruchtlichaam zich heeft ontwikkeld. Een expert kan de lange schimmeldraden doelgericht opsporen.

Wat zijn de verschillen tussen huiszwam en kelderzwam?
Zowel de huiszwam als de kelderzwam vormen een heus gevaar voor je woning. Maar hoe weet je of er inderdaad sprake is van de een of de ander?
Een eerste indicatie is waar de zwam zich bevindt. Hoewel beide soorten schimmels de voorkeur geven aan naald- en loofhout, heeft de kelderzwam meer vocht nodig dan de huiszwam. De kelderzwam zie je dan ook het vaakst terug in vochtige kelders met optrekkend vocht en kruipruimtes. Kelderzwammen staan ook bekend als natrot.
De huiszwam houdt ook van vocht, maar heeft minder vocht nodig om te overleven. De huiszwam wordt daarom ook droogrot genoemd.
Ook de kleur van de huiszwam kan verraden om welke soort het gaat. De huiszwam heeft een roodachtige kleur, de kelderzwam is donkerbruin.
Tot slot verspreidt de huiszwam zich sneller dan de kelderzwam. Het is een agressievere soort, waarvan de schimmeldraden zich dieper in het aangetaste hout dringen.
Hoe ontstaat een zwam in je huis?
Huiszwammen hebben vocht en cellulose nodig. Ze geven de voorkeur aan houten oppervlakken, maar de huiszwam gedijt ook goed op papier of karton. Twee zaken werken de groei van huiszwam in de hand:
- Vocht: Vocht in huis is de grootste oorzaak voor zwamgroei. Denk maar aan doorslaand of opstijgend vocht. Ook een lekkage in een leiding of het dak kan voor lelijke schimmel zorgen. Hout met een vochtpercentage van minstens 20 % volstaat.
- Gebrekkige ventilatie: Slechte ventilatie kan een vochtprobleem verergeren. Bij slechte ventilatie krijg je een hoge luchtvochtigheid. Een luchtvochtigheid van meer dan 70 procent is ideaal voor zwammen.
Daarnaast houdt de zwam ook van weinig lichtinval en de aanwezigheid van naald- of loofhout. De ideale temperatuur voor zwammen ligt rond de 20 graden. Vandaar dat de zwam vaak in woningen voorkomt.
Enkele plekken waar je de huiszwam kan aantreffen:
- Zolders
- Keukens
- Badkamers
- Afgesloten ruimtes, bijvoorbeeld een kruipruimte, al is de kelderzwam hier vaker aanwezig
- Een warme kelder

Wat zijn de gevolgen van huiszwam?
De aanwezigheid van zwammen heeft heel wat gevaarlijke gevolgen.
Huiszwam: schade aan woning
De huiszwam gedijt vooral bij hout, zoals eerder gezegd. Meubels en constructieonderdelen van hout gemaakt, lopen dan ook het grootste gevaar op aantasting.
De lange schimmeldraden dringen diep binnen in het hout. Het vruchtlichaam voedt zich met cellulose, dat uit het hout onttrekt. Het aangetaste hout rot en wordt week. Dat fenomeen wordt ‘bruinrot’ genoemd, omdat het hout steeds donkerder en soms zelfs zwart wordt. Er verschijnen krimpscheuren, en na verloop van tijd verpoederd het hout.
Daarnaast kan de zwam zich snel verspreiden. Dat kan zowel naar andere houten onderdelen, als over het houten oppervlak waar de sporen aanvankelijk ontkiemden.
Gaat het om een houten raamkozijn? Dan laat je dat best vervangen. De bestrijding is ingewikkelder wanneer bijvoorbeeld houten steunbalken zijn aangetast.
Niet enkel hout loopt gevaar. Bij ernstige zwamgroei kan zelfs steen en beton worden aangetast. Verflagen en behangpapier komen los, pleisterwerk brokkelt af, en zelfs het metsel- en voegwerk kan verzwakken.
Woningen uit houtskeletbouw lopen het grootste gevaar. De zwam kan de constructie en stabiliteit van je woning in gevaar brengen. Bij zware aantasting ontstaat er schade aan de structuur en valt de woning niet meer te redden. Een drastische renovatie is dan de enige oplossing.
Precies daarom is het van groot belang om op tijd in te grijpen. Zodra je zwammen aantreft, moet je professionele hulp van een specialist inschakelen.
Is huiszwam giftig en gevaarlijk voor je gezondheid?
Voor je gezondheid is de huiszwam geen goed nieuws. Net als schimmels verspreiden zwammen giftige stoffen die schade aanrichten. Voorbeelden van ernstige gezondheidsklachten zijn:
- Aandoeningen van de luchtwegen
- Ademhalingsproblemen
- Allergische reacties
- Huidirritatie (jeuk, eczeem kan verergeren)
- Verzwakking van het immuunsysteem
De risico’s zijn het grootst voor jonge kinderen, ouderen, mensen met onderliggende aandoeningen en mensen met een verminderde immuniteit.
Wat kan je doen tegen huiszwam? [stappenplan]
Wat doe je als je de huiszwam aantreft? Met dit stappenplan krijg je een beeld van de stappen die je moet doorlopen om de plaag te bestrijden.
Stap 1: Ongediertebestrijder inschakelen
Huiszwam aangetroffen? Bel dan een ongediertebestrijder op. Die inspecteert de mate van verspreiding en aantasting. Daarvoor gebruikt de expert speciale apparatuur. Aan de hand van de bevindingen stelt de bestrijder een behandelplan op.
Stap 2: Vochtproblemen aanpakken
Zwammen zijn nagenoeg altijd het gevolg van een vochtprobleem. Het is noodzakelijk om het onderliggende vochtprobleem aan te pakken. Bijvoorbeeld door de muren te injecteren tegen opstijgend vocht of de gevel te impregneren tegen doorslaand vocht.
Stap 3: Bestrijden en behandelen van huiszwam
De vruchtlichamen worden vakkundig verwijderd. Het kan nodig zijn om het aangetaste hout tot tientallen centimeters rond de aantasting weg te snijden. Ernstig aangetaste oppervlakken moeten soms volledig verwijderd worden.
Tijdens het verwijderen van aangetaste oppervlakken gaat de bestrijder nauwkeurig te werk. Aangetast materiaal mag niet in aanraking komen met onaangetast materiaal. Zo vermijdt de expert een nieuwe plaag.
Na het verwijderen van de zwam worden resterende oppervlakken behandeld met een zwamdodend middel. Zo vermijd je het ontkiemen van nieuwe sporen.
Stap 4: Voorbehandelen en vervangen van aangetaste materialen
Tot slot worden aangetaste en verwijderde materialen hersteld of vervangen. Het zal voornamelijk om houten onderdelen gaan. Soms is het ook nodig pleisterwerk te vervangen.
Nieuw hout wordt preventief behandeld met verduurzamingsmiddel.
Preventie: hoe kun je huiszwam voorkomen?
Je wilt een probleem met zwammen liever vermijden dan bestrijden. Met deze tips bescherm je jouw woning tegen de huiszwam:
- Laat vochtproblemen niet aanslepen. Grijp bij een vochtprobleem, zoals bijvoorbeeld opstijgend vocht, zo snel mogelijk in.
- Zorg voor voldoende, goede ventilatie.
- Houd de luchtvochtigheid laag.
- Behandel houten constructieonderdelen en zelfs meubels met een verduurzamingsmiddel.
Kun je huiszwam bestrijden met azijn? In een vroeg stadium (dus voor je de vruchtlichamen ziet) kan azijn enigszins helpen. Azijn kan de schimmeldraden beschadigen en zelfs doen afsterven.
Het is echter niet aan te raden om er op te vertrouwen dat hiermee een huiszwam definitief voorkomen is. De huiszwam verwijderen met kant-en-klare bestrijdingsmiddelen gaat niet zomaar. De schimmeldraden zijn bijvoorbeeld niet altijd met het blote oog waarneembaar. Ze kunnen zich diep in het hout verstoppen. Je belt altijd best een specialist om het probleem te analyseren.
Huiszwammen laten verwijderen door een echte professional? Vergelijk gratis offertes
Voorkom verdere aangetaste ruimtes en houten constructies. Doe altijd beroep op een professionele vochtbestrijder om huiszwam te bestrijden.